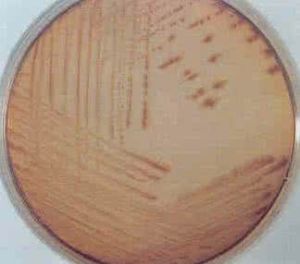
鹽胞菌屬 鹽胞菌屬

鹽胞菌屬
發酵碳水化合物,不利用肽和胺基酸。 DNA的G+C mol%是29±1。細胞脂類包括脂肪酸、羥基脂肪酸和醛,有直鏈和支鏈兩類。脂的主要成分是不飽和脂
模式種(惟一種):
解纖維鹽胞菌(Halocella cellulolytica)。
鹽胞菌屬拉丁學名(Halocella Malmqvist et al.,1997) 桿菌,革蘭氏陰性,不產芽孢,嚴格厭氧,中度嗜鹽。
發酵碳水化合物,不利用肽和胺基酸。 DNA的G+C mol%是29±1。細胞脂類包括脂肪酸、羥基脂肪酸和醛,有直鏈和支鏈兩類。脂的主要成分是不飽和脂
解纖維鹽胞菌(Halocella cellulolytica)。
海單胞菌屬拉丁學名【Marinomonas(Bamann et al.)Van Landschoot and Delay,1983】 直或彎的桿菌,0....
海單胞菌屬 模式種:AS 1.1778.關鍵字 假單胞菌屬, 鹽敏假單胞 菌Key期刊 微生物...發表文章 假單胞菌屬的一個新種Article A New Species...9191的革蘭氏陰性短桿菌, 其形態, 生理生化特性 與假單胞菌屬已報導的種...
基本信息 作者信息 摘要 保存單位 備註短波單胞菌屬拉丁學名(Brevundimonas Segers et al.,1994) Segers等於1994根據全細胞蛋白電泳圖譜、脂肪酸組成和表...
分類 套用嗜鹽菌(Halophiles)又稱作副溶血性弧菌是生活在高鹽度環境中的一類古細菌。
分類 適應機理 排鹽作用 中毒 診斷治療古菌可能是最古老的生命體,古菌一些奇特的生活習性和與此相關的潛在生物技術開發前景,長期以來一直吸引著許多人的注意。古菌常被發現生活於各種極端自然環境下,...
形態 細胞結構 代謝 繁殖方式 生活習性其他沙門菌感染是由各種沙門菌(Salmonellae)所引起的急性傳染病。
流行病學 病因 發病機制 臨床表現 診斷李斯特氏菌屬有7個菌種,即單核細胞增生李斯特氏菌,綿羊李斯特氏菌,英諾克李斯特氏菌,威爾斯李斯特氏菌 ,西爾李斯特氏菌 ,格氏李斯特氏菌 ,莫氏李斯特氏菌
基本信息 生化反應無芽胞厭氧菌,包括多種革蘭陰性和革蘭陽性厭氧菌,大多為人體正常菌群重要組成部分,其致病力不強,為條件致病菌。在因手術、拔牙、腸穿孔等原因,使屏障作用受損...
物種簡介 感染特徵 厭氧性球菌 陰性無芽胞 陽性無芽胞